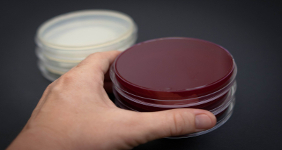
Microbiology laboratory service

BioChroma Analytical Labs, LLC
BioChroma Analytical Labs, LLC is based out of the DFW metroplex in the heart of Texas. It was created to fill the technical gaps in new product development for innovators with new ideas that might not have all the necessary components to make it happen and to offer support for product quality through analytical testing and consulting.
We provide an all-encompassing service to help our clients develop a product that is continually manufactured to the level of quality customers expect. Our goal is to provide continual scientific and technical support for entrepreneurs and established businesses based on quality at an affordable price. We are here to provide technical assistance to foster their idea from inception to the marketplace and beyond.
We have experience and expertise in research and development, formulations, scale-up, testing, quality, and regulatory support for a wide variety of consumer products in the areas of cosmetics, skin care, topical and oral OTCs, food, beverages, dietary supplements, household cleaners, and the like.
BioChroma provides third-party analytical testing and related support for product quality, regulatory, and marketplace compliance. Some clients use this work to support products sold through online marketplaces such as Amazon.
Below is a brief overview of some products and services offered:
- Product Research and Development: Skin, Body, Hair Care Development, Dietary Supplement Development
- Consulting: Packaging Advice, Manufacturing Advice, Plant Inspections, Ingredient Stability Advice, Container Closure Advice, Product Formulation Advice, Quality and Regulatory Advice
- Chemistry Analysis: Nutritional Analysis, Mineral Analysis, Vitamin Analysis, Preservative Analysis, Active Ingredient Analysis, Allergen Analysis.
- Microbiological Analysis: General Microbiology Analysis, Pathogenic Bacteria Analysis, Spoilage Organism Analysis, Preservative Efficacy Analysis, Bacterial Challenge Studies, In vitro Time-Kill Studies, Antibiotic Studies, Water Suitability Testing
- Laboratory Research and Development: Transdermal Studies, Antimicrobial Efficacy, Product Specific Studies Aimed at Demonstrating Efficacy or Quality